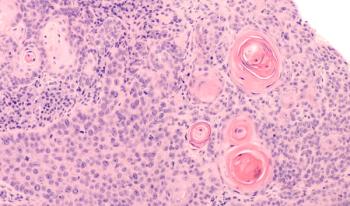

This week's edition of the Mainstream Patient features stories about how to treat melasma, an honest reflection on skin picking, the beauty in breast cancer scars, and more.

This week's edition of the Mainstream Patient features stories about how to treat melasma, an honest reflection on skin picking, the beauty in breast cancer scars, and more.

Christopher Bunick, MD, PhD, discusses the 5th personal care product category recall, dry shampoos, due to heightened levels of benzene.

At the 2022 Fall Clinical Dermatology Conference, Bruce E. Strober, MD, PhD, reviewed the best treatment options for patients with psoriasis and psoriatic arthritis.

At the 2022 Fall Clinical Dermatology Conference, 3 expert clinicians share their strategies for diagnosing and managing alopecia areata.

The 40-gene expression profile (40-GEP) test can focus treatment options and optimize patient outcomes, according to a poster presentation at the 2022 Fall Clinical Dermatology Conference.

At the 2022 Fall Clinical Dermatology Conference, Joslyn R. Sciacca Kirby, MD, MS, MEd, and Raj Chovatiya, MD, PhD, discussed how there is a large unmet need for hidradenitis suppurativa treatment and what future treatment could look like.

Aaron Farberg, MD, presents study data and efficacy of spesolimab for the treatment of generalized pustular psoriasis at the 2022 Fall Clinical Dermatology Conference.

At the 2022 Fall Clinical Dermatology Conference, Valerie D. Callender, MD, FAAD, presents “What’s Hot in Acne & Rosacea.”

Lisa Swanson, MD, FAAD, and James Q. Del Rosso, DO, FAOCD, FAAD, gave an in-depth discussion on Janus kinase (JAK) inhibitors for the management of atopic dermatitis at the 2022 Fall Clinical Dermatology Conference.

As the 2022 Fall Clinical Dermatology Conference begins this week, Heathy Ivy, DO, regional medical director for LaserAway in Atlanta, Georgia, shares why she is looking forward to attending Fall Clinical.

The 2022 Fall Clinical Dermatology Conference begins today in Las Vegas, Nevada, and continues through October 23rd.

Alphyn Biologics’ study of AB-101a also evaluates patients who suffer from bacterial infections associated with atopic dermatitis.

This week's edition of the Mainstream Patient features stories about skin care routines for dry skin, what it's like living with psoriasis, how to take care of skin during breast cancer treatment, and more.

Click to see a preview of what to expect this week.

ICYMI, this week we had stories about the American Society for Dermatologic Surgery Meeting, pediatric nail disorders, generalized pustular psoriasis treatment, and more.

Patients with generalized pustular psoriasis flares were 2 times more likely to have emergency department visits.

Catch up on coverage from the editors of Dermatology Times® who attended the annual ASDS Meeting.

Saranya Wyles, MD, PhD, takes a closer look at skin aging, cellular senescence, and emerging regenerative medicine techniques at the 2022 Annual ASDS Meeting.

Immune checkpoint inhibitor therapy does not appear to increase complication rates in patients undergoing dermatologic procedures, according to a video oral abstract presentation at the 2022 ASDS Annual Meeting.

The legacy of the late Vic Narurkar, MD, and his commitment to aesthetics was honored at the 2022 Annual ASDS Meeting.

At the 2022 Annual ASDS Meeting, Mona Gohara, MD, highlights the importance of diversity, equity, and inclusion in the field of dermatology.

At the Melanoma Update of the Annual ASDS Meeting, Tyler Hollmig, MD, looked at complex clinical scenarios when treating melanoma and the continued challenges dermatologists face.
Sherrif Ibrahim, MD, PhD, provides key pearls from his co-directed session at the 2022 Annual ASDS Meeting, “Defining ‘High-Risk’ for Squamous Cell Carcinoma: Implications for Treatment Paradigms.”

Mona Gohara, MD, gives an overview and 3 highlights from her presentation, “How to Build and Design a Dermatologic Practice,” at the 2022 ASDS Annual Meeting.

Kimberly Ken, MD, assistant professor of dermatology at Penn State University, discussed crucial methods for advanced melanoma management.

Mona Sadeghpour, MD, FAAD, chair of the State of Affairs Work Group of ASDSA, spoke at the American Society for Dermatologic Surgery Meeting about how dermatologists can stay involved in dermatologic advocacy.

Patricia Farris, MD, dermatologist from Metairie, Louisiana, discusses key pearls from her presentation at the American Society for Dermatologic Surgery (ASDS) Meeting.

As the American Society for Dermatologic Surgery (ASDS) Annual Meeting begins today, Sue Ellen Cox, MD, president of ASDS, participated in a Q&A session.

Patricia Farris, MD, dermatologist from Metairie, Louisiana, discusses why the American Society for Dermatologic Surgery (ASDS) Annual Meeting is one of her favorite conferences to attend.

The 2022 American Society for Dermatologic Surgery (ASDS) Annual Meeting officially begins today in Denver, Colorado, and continues through October 10th.